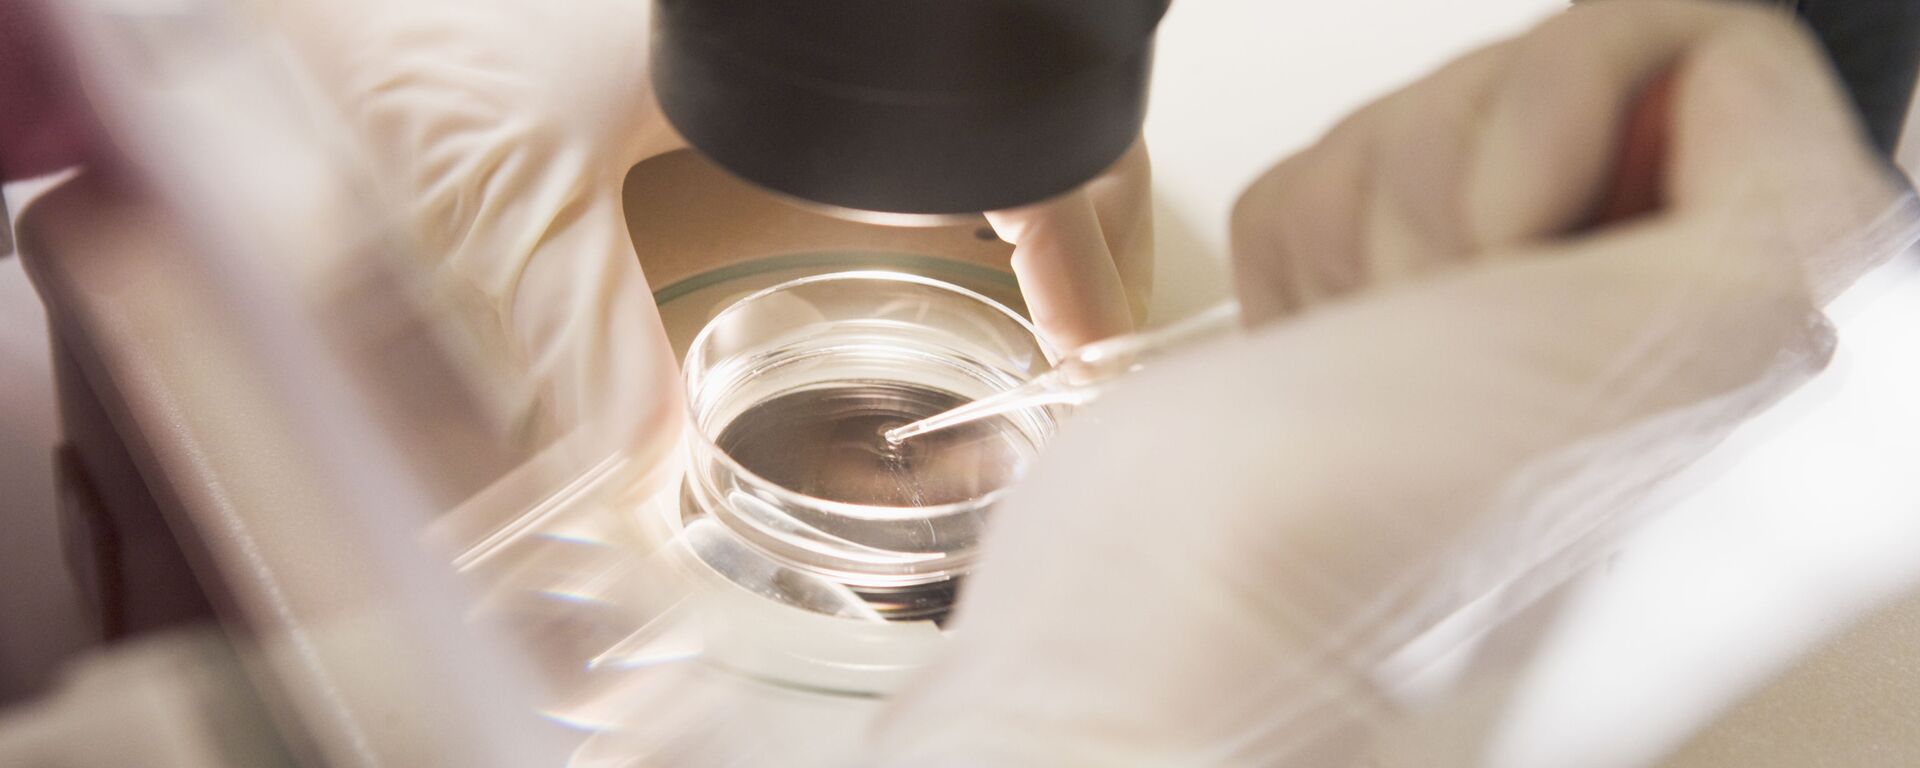
Thụ tinh trong ống nghiệm - Sputnik Việt Nam, 1920, 09.09.2025

https://kevesko.vn/20250915/cac-nha-khoa-hoc-nga-tim-ra-cach-giam-nguy-co-ung-thu-lien-quan-den-thu-tinh-trong-ong-nghiem--38332245.html
Các nhà khoa học Nga tìm ra cách giảm nguy cơ ung thư liên quan đến thụ tinh trong ống nghiệm
Các nhà khoa học Nga tìm ra cách giảm nguy cơ ung thư liên quan đến thụ tinh trong ống nghiệm
Sputnik Việt Nam
Dữ liệu mới do các nhà khoa học từ Đại học Quốc gia Surgut (SurSU) thu thập có thể giúp giảm nguy cơ phát triển ung thư vú ở những phụ nữ điều trị vô sinh... 15.09.2025, Sputnik Việt Nam
2025-09-15T19:40+0700
2025-09-15T19:40+0700
2025-09-15T19:40+0700
khoa học
nhà khoa học
nga
ung thư
https://cdn.img.kevesko.vn/img/562/43/5624372_0:160:3072:1888_1920x0_80_0_0_96dc2f4567ba28844e973137fd9588ee.jpg
Các phương pháp điều trị vô sinh hiện đại, đặc biệt là thụ tinh trong ống nghiệm (IVF), bao gồm kích thích buồng trứng mạnh mẽ để thu được nhiều trứng có chất lượng tốt hơn trong một chu kỳ. Theo các nhà khoa học từ Đại học Quốc gia Surgut (SurSU), sự can thiệp này tạo ra gánh nặng lớn cho cơ thể và có thể dẫn đến ung thư.Các chuyên gia của Đại học SurSU đã tiến hành một nghiên cứu để xác định các phương pháp giảm thiểu những rủi ro này. Sau khi phân tích độ tuổi của từng bệnh nhân, thời gian vô sinh, tình trạng bệnh phụ khoa và tình trạng ban đầu của tuyến vú, các nhà nghiên cứu nhận thấy rằng, tình trạng ban đầu của tuyến vú có tầm quan trọng lớn nhất.Theo bà Klimova, kết quả nghiên cứu cho thấy rằng, nguy cơ phát triển ung thư vú cao nhất trong vòng 10 năm tới sau khi sử dụng liệu pháp hormone được dự đoán ở những phụ nữ có khối u loạn sản lành tính và khối u xơ tuyến vú. Xác suất ung thư ở những khối u này lần lượt là 13,4% và 16,7%, trong khi nếu không có bệnh lý, nguy cơ chỉ được ước tính là 0,3%.Theo các chuyên gia của SurSU, điều này xác định nhu cầu khám vú bắt buộc ở các giai đoạn chuẩn bị điều trị và trong suốt quá trình thực hiện điều tri vô sinh. Việc phát hiện và điều trị kịp thời các quá trình bệnh lý sẽ làm giảm nguy cơ phát triển khối u.Không giống như các mô hình hiện có để đánh giá rủi ro ung thư vú dựa trên độ tuổi, yếu tố di truyền và dữ liệu sinh thiết, các nhà nghiên cứu từ Đại học SurSU bổ sung thêm dữ liệu về tác động của nhiều đợt kích thích hormone điều trị vô sinh và tình trạng ban đầu của tuyến vú dựa trên dữ liệu từ chụp nhũ ảnh và siêu âm.Trong tương lai gần, các nhà khoa học dự định tạo ra một máy tính để đánh giá nguy cơ ung thư vú cho từng cá nhân. Theo họ, công cụ này sẽ cải thiện tính an toàn của các công nghệ điều trị vô sinh dựa trên chẩn đoán kịp thời và sẽ giúp phát triển các biện pháp phòng ngừa được cá nhân hóa cho từng bệnh nhân.Kết quả nghiên cứu dựa trên việc phân tích dữ liệu từ 4.500 bệnh nhân. Ở giai đoạn hiện tại của nghiên cứu, các nhà khoa học SurSU dự định mở rộng quy mô mẫu và tiếp tục quan sát để tinh chỉnh mô hình tiên lượng. Họ cũng có kế hoạch xây dựng hệ thống khuyến nghị và thuật toán để thực hiện các xét nghiệm vú, giúp bác sĩ và bệnh nhân đưa ra quyết định đúng đắn hơn.Cuộc nghiên cứu này là một phần của dự án công nghệ chiến lược đang được thực hiện tại Đại học SurSU mang tên "Giải pháp y sinh cho y học cá nhân hóa" thuộc chương trình liên bang "Ưu tiên-2030" của dự án quốc gia "Thanh niên và Trẻ em".
https://kevesko.vn/20250909/cac-nha-khoa-hoc-nga-phat-hien-co-che-mien-dich-lam-tang-co-hoi-thanh-cong-cua-thu-tinh-ong-nghiem-38201174.html
https://kevesko.vn/20250819/cac-nha-khoa-hoc-nga-da-tang-cuong-suc-manh-cho-pin-nhien-lieu-vi-sinh-vat-37764049.html
Sputnik Việt Nam
moderator.vn@sputniknews.com
+74956456601
MIA „Rossiya Segodnya“
2025
Sputnik Việt Nam
moderator.vn@sputniknews.com
+74956456601
MIA „Rossiya Segodnya“
tin thời sự
vn_VN
Sputnik Việt Nam
moderator.vn@sputniknews.com
+74956456601
MIA „Rossiya Segodnya“
Sputnik Việt Nam
moderator.vn@sputniknews.com
+74956456601
MIA „Rossiya Segodnya“
khoa học, nhà khoa học, nga, ung thư
khoa học, nhà khoa học, nga, ung thư
Các nhà khoa học Nga tìm ra cách giảm nguy cơ ung thư liên quan đến thụ tinh trong ống nghiệm
Dữ liệu mới do các nhà khoa học từ Đại học Quốc gia Surgut (SurSU) thu thập có thể giúp giảm nguy cơ phát triển ung thư vú ở những phụ nữ điều trị vô sinh bằng liệu pháp hormone. Kết quả nghiên cứu được công bố trên tạp chí "Russian Bulletin of Obstetrician-Gynecologist".
Các phương pháp điều trị vô sinh hiện đại, đặc biệt là thụ tinh trong ống nghiệm (
IVF), bao gồm kích thích buồng trứng mạnh mẽ để thu được nhiều trứng có chất lượng tốt hơn trong một chu kỳ. Theo các nhà khoa học từ Đại học Quốc gia Surgut (SurSU), sự can thiệp này tạo ra gánh nặng lớn cho cơ thể và có thể dẫn đến ung thư.
Các chuyên gia của Đại học SurSU đã tiến hành một
nghiên cứu để xác định các phương pháp giảm thiểu những rủi ro này. Sau khi phân tích độ tuổi của từng bệnh nhân, thời gian vô sinh, tình trạng bệnh phụ khoa và tình trạng ban đầu của tuyến vú, các nhà nghiên cứu nhận thấy rằng, tình trạng ban đầu của tuyến vú có tầm quan trọng lớn nhất.
"Nếu một phụ nữ có những thay đổi lành tính hoặc mật độ cao của mô vú trên chụp nhũ ảnh, thì việc kích thích bằng nhiều hormone trở thành yếu tố rủi ro đáng kể nhất", - Giáo sư Natalia Klimova, Khoa Phẫu thuật tại Đại học SurSU, cho biết.
Theo bà Klimova, kết quả nghiên cứu cho thấy rằng, nguy cơ phát triển ung thư vú cao nhất trong vòng 10 năm tới sau khi sử dụng liệu pháp hormone được dự đoán ở những phụ nữ có khối u loạn sản lành tính và khối u xơ tuyến vú. Xác suất ung thư ở những khối u này lần lượt là 13,4% và 16,7%, trong khi nếu không có bệnh lý, nguy cơ chỉ được ước tính là 0,3%.
Theo các chuyên gia của SurSU, điều này xác định nhu cầu khám vú bắt buộc ở các giai đoạn chuẩn bị điều trị và trong suốt quá trình thực hiện điều tri vô sinh. Việc phát hiện và điều trị kịp thời các quá trình bệnh lý sẽ làm giảm nguy cơ phát triển khối u.
Không giống như các mô hình hiện có để đánh giá rủi ro ung thư vú dựa trên độ tuổi, yếu tố di truyền và dữ liệu sinh thiết, các nhà nghiên cứu từ Đại học SurSU bổ sung thêm dữ liệu về tác động của nhiều đợt kích thích hormone điều trị vô sinh và tình trạng ban đầu của tuyến vú dựa trên dữ liệu từ chụp nhũ ảnh và siêu âm.
Trong tương lai gần, các nhà khoa học dự định tạo ra một máy tính để đánh giá
nguy cơ ung thư vú cho từng cá nhân. Theo họ, công cụ này sẽ cải thiện tính an toàn của các công nghệ điều trị vô sinh dựa trên chẩn đoán kịp thời và sẽ giúp phát triển các biện pháp phòng ngừa được cá nhân hóa cho từng bệnh nhân.
Kết quả nghiên cứu dựa trên việc phân tích dữ liệu từ 4.500 bệnh nhân. Ở giai đoạn hiện tại của nghiên cứu, các nhà khoa học SurSU dự định mở rộng quy mô mẫu và tiếp tục quan sát để tinh chỉnh mô hình tiên lượng. Họ cũng có kế hoạch xây dựng hệ thống khuyến nghị và thuật toán để thực hiện các xét nghiệm vú, giúp bác sĩ và bệnh nhân đưa ra quyết định đúng đắn hơn.
Cuộc nghiên cứu này là một phần của dự án công nghệ chiến lược đang được thực hiện tại Đại học SurSU mang tên "Giải pháp y sinh cho y học cá nhân hóa" thuộc chương trình liên bang "Ưu tiên-2030" của dự án quốc gia "Thanh niên và Trẻ em".